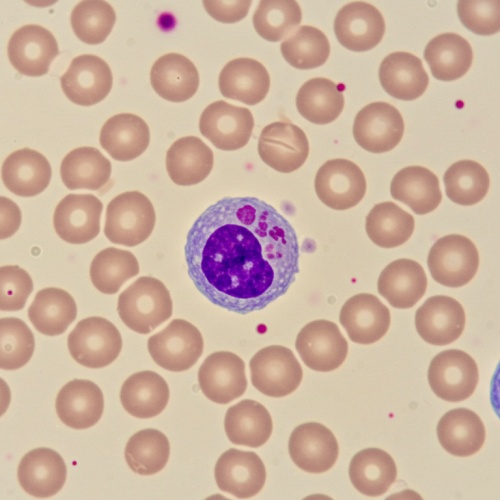
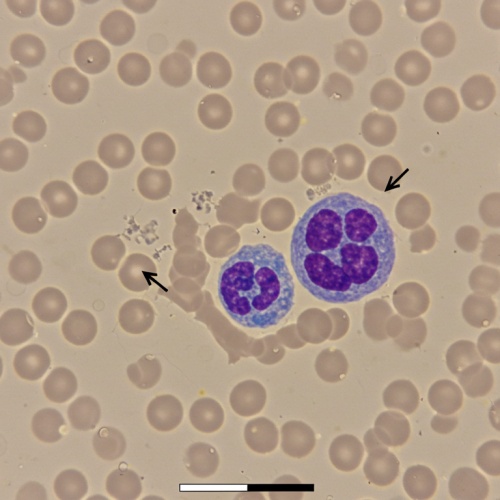

건강검진에서 “백혈구 수치 낮음(WBC 감소)”이라는 말을 들으면 누구나 놀랍니다. 이 글은 백혈구 수치가 낮아지는 이유와 함께 **호중구감소증(ANC)**을 쉽게 정리해, 언제 병원에 가야 하는지, 어떤 검사가 필요한지 한눈에 이해하도록 돕습니다.
백혈구와 호중구, 무엇이 다른가?

- 백혈구(WBC): 우리 몸의 감염 방어군 전체를 의미합니다. 검사실마다 정상 범위가 조금씩 다르지만 보통 약 4,500–10,000/μL로 제시됩니다.
- 호중구(Neutrophil): 백혈구 중 가장 비중이 큰 세력으로 세균·곰팡이 방어의 핵심입니다. **절대호중구수(ANC)**로 감염 위험을 가늠합니다.
- 경도: 1,000–1,500/μL
- 중등도: 500–1,000/μL
- 중증: <500/μL (감염 위험 급증)
백혈구 수치가 낮아지는 대표 원인 10가지

- 감염: 독감 같은 바이러스부터 결핵·패혈증 등까지, 일시적 또는 지속적 저하를 유발할 수 있음.
- 약물·치료 영향: 항암화학요법, 방사선치료, 일부 항생제·항정신병약·면역억제제 등으로 골수 억제 발생.
- 자가면역질환: 전신홍반루푸스(SLE), 류마티스관절염 등에서 백혈구 감소 동반 가능.
- 골수질환/암: 백혈병, 림프종, 골수형성부전 등 조혈 기능 자체의 문제.
- 골수기능 부전(재생불량성빈혈): 적혈구·백혈구·혈소판 모두 감소하는 경우가 흔함.
- 영양결핍: 비타민 B12·엽산 부족은 조혈 감소로 WBC 저하 유발.
- 만성질환: 간질환, 비장 비대, 사르코이드증 등 전신 질환의 영향.
- 유전적/체질적 요인: 선천성·주기성 호중구감소증, 일부 인종에서의 체질적 저호중구증 등.
- 생활요인: 장기적인 영양불량, 과음, 심한 스트레스, 수면부족 등이 조혈에 악영향.
- 특발성(원인 불명): 검사로도 뚜렷한 원인이 확인되지 않는 경우.
참고 영상
핵심: 원인이 매우 다양하므로, 문진+검사로 특정해야 정확한 대처가 가능합니다.
나타날 수 있는 증상

- 반복되는 감염, 발열, 오한, 인후통
- 재발하는 구내염/치통, 피부발진
- 피로감, 몸살 같은 전신 증상
- 무증상으로 우연히 발견되는 경우도 흔함
병원에 바로 가야 하는 경우(응급 신호)

- **발열(≥38.0–38.3°C)**이 있으면서 백혈구가 낮다고 들은 경우
- 중증 호중구감소(ANC <500/μL) 또는 최근 급격한 감소
- 심한 오한, 의식 변화, 호흡곤란 등 패혈증 의심 증상
→ 신속한 평가와 경험적 항생제 치료가 필요할 수 있습니다.
어떤 검사를 하나요?

- CBC(전혈구검사) + 분획 + 말초도말: 총수·분획비·형태 이상 확인(변동성 있으니 반복 측정 권장).
- 영양 평가: 비타민 B12·엽산·철 결핍 확인.
- 감염 평가: 필요 시 간염·HIV 등 병원체 검사.
- 자가면역·간/비장 평가: 필요 시 자가항체, 복부초음파 등.
- 골수검사: 원인 의심 시 선택적으로 시행.
치료와 관리

- 원인 교정이 최우선: 약물 조정/중단, 감염 치료, 영양 보충, 자가면역 치료 등.
- 감염 예방법(ANC <500/μL 주의)
- 손위생, 상처 즉시 소독, 군중·밀폐공간 회피
- 구강 위생 강화(칫솔 부드럽게, 구강세정)
- 예방접종 이력 점검(주치의와 상의)
- 전문 치료: 항암치료 관련 저하에서는 G-CSF 투여, 항생제 예방, 스케줄 조정 등을 고려.
- 생활 관리: 단백질·비타민이 풍부한 식사, 규칙적인 수면, 과음·흡연 줄이기.
집에서 체크할 포인트

- 최근 새로 시작한 약 또는 용량 변경이 있었는가?
- 열·오한·구내염이 반복되는가?
- 체중 감소, 멍이 잘 듦, 심한 피로 등 다른 혈구 이상 신호가 있는가?
- 1~2주 간격 재검에서 수치가 계속 내려가고 있는가?
중간 요약

- 백혈구 수치 낮은 이유는 감염, 약물, 자가면역, 영양결핍, 골수질환 등 폭넓습니다.
- ANC가 1,000 미만이면 감염 위험이 늘고, 500 미만은 고위험입니다.
- CBC 재확인 + 원인 평가가 핵심이며, 발열 동반 시 지체 금물입니다.
자주 묻는 질문(FAQ)

Q1. 검사에서 잠깐 낮게 나왔다가 정상으로 돌아오면 괜찮나요?
A. 하루·상황에 따라 변동할 수 있어 반복 측정으로 추세를 봐야 합니다. 증상·병력에 따라 추가 평가가 필요합니다.
Q2. 정상 WBC여도 호중구만 낮을 수 있나요?
A. 가능합니다. 그래서 ANC(절대호중구수) 확인이 중요합니다.
Q3. 어느 수준부터 위험한가요?
A. 일반적으로 ANC 1,000 미만부터 감염 위험이 증가하고, <500/μL는 고위험으로 봅니다. 발열이 동반되면 즉시 진료를 받으세요.
Q4. 영양제로 해결되나요?
A. B12·엽산 결핍이 원인인 경우에는 도움이 되지만, 원인이 다양하므로 검사 후 맞춤 치료가 필요합니다.
Q5. 항암치료 중인데 WBC가 낮아요. 어떻게 하나요?
A. 항암·방사선치료는 흔한 원인입니다. 의사가 G-CSF, 항생제 예방, 치료 스케줄 조정 등을 검토합니다. 발열 시 응급 평가 대상입니다.
결론















“백혈구 수치 낮음”은 한 가지 원인으로 단정할 수 없습니다. 증상(특히 발열) 유무와 ANC 수치가 향후 계획을 결정합니다. 최근 결과가 걱정된다면 CBC 재검과 함께 분획/도말, 영양·감염·자가면역 평가를 주치의와 상의하세요. 빠른 확인이 불필요한 불안을 줄이고, 필요한 경우 적기 치료로 연결됩니다.
이 글은 의료 정보를 제공하기 위한 것으로, 전문적인 진단·치료를 대체하지 않습니다. 급성 증상이나 발열이 있으면 즉시 의료기관을 방문하세요.
함께 보면 좋은 정보
ALT AST 수치
ALT AST 수치 한눈에 보기AST·ALT는 간세포 손상 시 혈중으로 새는 효소예요.정상 범위는 기관마다 다르지만 ALT는 대략 7–55 U/L, AST는 8–48 U/L가 흔합니다(※ 결과지 참고치 우선).**AST/ALT 비율(De Riti
charlie.aqatree.com
간수치가 높으면 나타나는 증상 총정리
하루 종일 피곤하고 속이 더부룩해서 걱정돼서 들어왔을 거예요. 이 글에서 간수치가 높으면 나타나는 증상과 간수치 정상범위 그리고 오늘부터 실천할 관리법을 쉽게 정리했습니다. 읽고 나면
charlie.aqatree.com
글루타치온 효능
오래 쌓인 피로, 균일하지 않은 피부 톤, 요즘 따라 신경 쓰이는 간 컨디션. 검색창에 손이 가면 가장 먼저 만나는 이름이 글루타치온이죠. “정말 도움이 될까? 어떻게 먹어야 할까? 부작용은 없
alpa.aqatree.com
마그네슘이 풍부한 음식 20가지|하루 식단과 함량표
영양·건강 주제로 글을 쓰는 블로거로서 가장 실용적인 정보를 모았어요. 왜 필요한지, 하루 권장량은 얼마인지, 어떤 음식을 얼마나 먹으면 채워지는지 숫자로 보여드렸어요. 놓치는 섭취 타
alpa.aqatree.com
포스파티딜 세린 효능 총정리
포스파티딜세린 효능, 실제 체감되는 포인트만 골라서 말씀드립니다.“요즘 기억력이 예전 같지 않다”는 말을 제 블로그에 가장 많이 남기세요. 저도 한때 회의 끝나고 돌아서면 이름·숫자가
charlie.aqatree.com